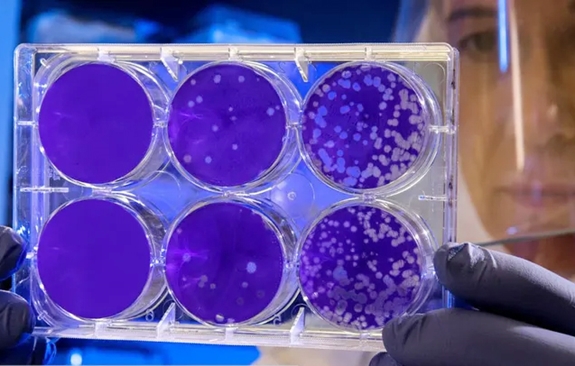

Khi phân tích qua kính hiển vi, các nhà khoa học thấy rằng, không giống các loài động vật khác, Henneguya salminicola không có bộ gen ty thể - bộ phận chứa các phân tử ADN nhỏ nhưng rất quan trọng nằm trong ty thể của động vật, bao gồm cả các gen có chức năng hô hấp.
Tương tự với loài ký sinh trùng thuộc lớp myxozoa – nhóm động vật ký sinh có cấu tạo đơn giản, sống trong môi trường nước và có họ xa với loài sứa, Henneguya salminicola trông giống tổ tiên của loài sứa, nhưng dần tiến hóa thành không có đặc điểm đa bào nào.
|
|
Nghiên cứu mẫu Henneguya salminicola trong phòng thí nghiệm. |
Tiến sĩ Dorothée Huchon, Đại học Tel Aviv, Israel, trưởng nhóm nghiên cứu cho biết: “Chúng không còn mô, cơ và không có tế bào thần kinh hay những thứ khác. Và chúng tôi vừa phát hiện chúng mất cả chức năng hô hấp”.
Việc lược bớt gen mang lại lợi thế cho các loài ký sinh trùng như Henneguya salminicola phát triển rất nhanh. Nhóm myxozoan sở hữu bộ gen nhỏ nhất trong thế giới động vật, giúp chúng hoạt động rất hiệu quả. Henneguya salminicola khá lành tính, không giống với hầu hết các loài ký sinh trùng cùng nhóm gây lây nhiễm và nguy cơ xóa sổ nhiều loài cá.
 |
|
Hình ảnh bào tử của Henneguya salminicola dưới kính hiển vi. |
Khi tách khỏi thịt của cá, Henneguya salminicola trông giống các đốm đơn bào hình tròn và có màu trắng (cá nhiễm Henneguya salminicola được cho là có “bệnh sắn”). Chỉ có bào tử của loài ký sinh trùng này cho thấy sự phức tạp hơn một chút. Dưới kính hiển vi, những bào tử này trông giống các tế bào tinh trùng có màu xanh với hai đuôi và một “đôi mắt” hình bầu dục.
“Đôi mắt” này thực chất là tế bào để chích vào động vật, chúng không có nọc nhưng giúp ký sinh trùng bám vào vật chủ khi cần. Đây là đặc điểm duy nhất mà Henneguya salminicola không loại bỏ trong quá trình tiến hóa.
Theo ông Huchon, động vật là những sinh vật đa bào với nhiều bộ gen và tiến hóa để đa dạng gen hơn, nhưng loài ký sinh trùng này lại đi ngược hoàn toàn, chúng tiến hóa gần như thành đơn bào.
|
|
|
Clip giải thích ban đầu về cơ chế hoạt động của loài Henneguya salminicola. |
Các loài ký sinh trùng tương tự đều có lượng protein để hấp thụ ATP (năng lượng phân tử) trực tiếp từ vật chủ và Henneguya salminicola cũng có thể chuyển hóa năng lượng theo cách này.
Các chuyên gia sẽ tiếp tục nghiên cứu thêm về bộ gen của Henneguya salminicola để biết thêm về quy trình hấp thụ năng lượng khi không cần hô hấp của chúng.
MAI HÀ (theo Live Science)